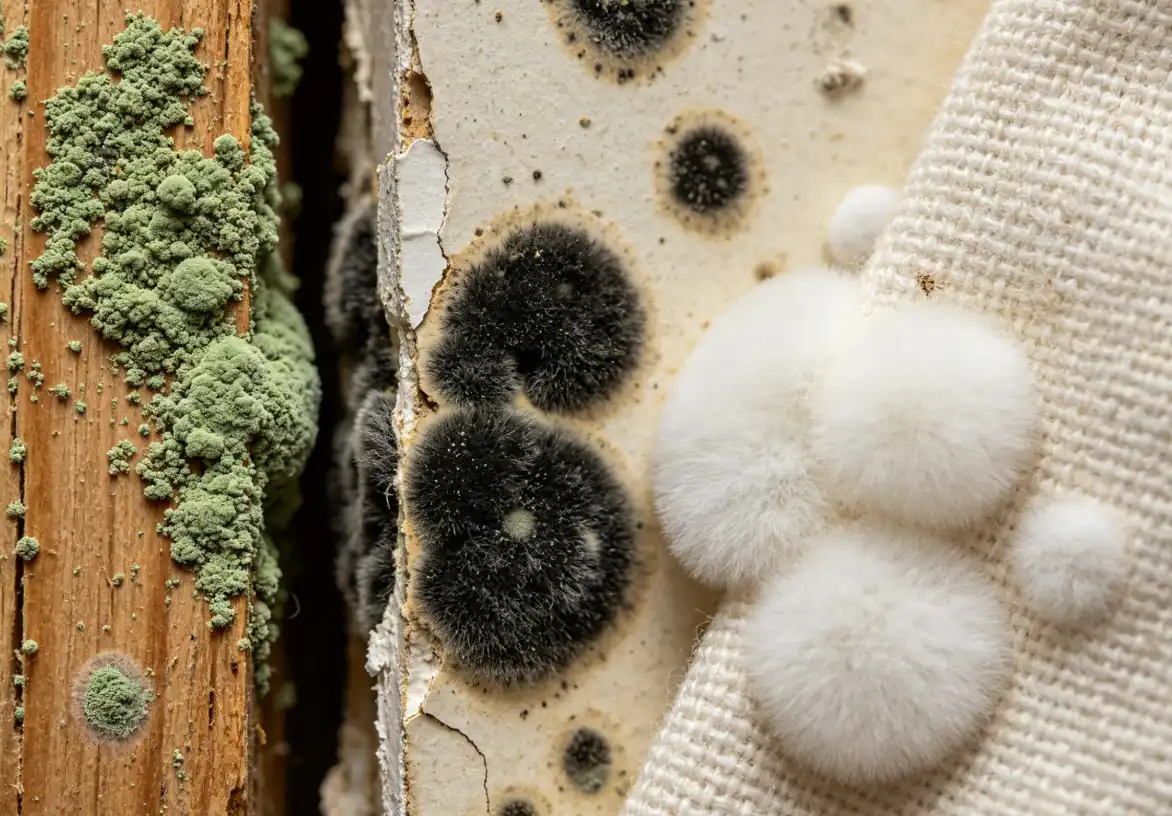
A close-up view showing the different colors and textures of common indoor molds like Aspergillus and Penicillium growing on household surfaces.

The EPA estimates that mold exists in roughly 50% of U.S. homes, yet most people only discover it after their nose picks up something off. So what does mold smell like? It produces a persistent musty, earthy odor—often compared to wet socks, rotting wood, or a damp basement—caused by microbial volatile organic compounds (MVOCs) that mold colonies release as they feed and grow. If you’ve caught an unexplained stale smell that won’t go away no matter how much you clean, this guide will help you identify the source, understand the health implications, and figure out exactly what to do next.
What Mold Smells Like in Simple Terms
Mold smells musty. That’s the short answer. If you’ve ever walked into a damp basement, opened a forgotten gym bag, or pulled a load of laundry that sat too long in the washer, you already know the scent. It’s stale, earthy, and slightly sour — the kind of smell that makes you wrinkle your nose before you can even name it.
So what does mold smell like in more specific terms? Think wet cardboard left in a garage for weeks. Or a pile of damp leaves decomposing on a forest floor. Some people compare it to dirty, wet socks stuffed into a closed shoe. Others say it reminds them of rotting wood or old library books that absorbed moisture over decades. The common thread across all these comparisons is dampness paired with organic decay.
That distinctive odor comes from chemical compounds called microbial volatile organic compounds (MVOCs), which mold colonies release as they feed on materials like drywall, wood, and fabric. According to the U.S. Environmental Protection Agency, these compounds are a reliable early indicator that mold is actively growing — even when you can’t see it yet. Your nose often detects a problem before your eyes do.
One detail worth knowing: the smell tends to get stronger in enclosed, poorly ventilated spaces. A closet, a crawl space under the house, the area behind a bathroom vanity. Crack open a door and that wave of staleness hits you immediately. If the odor fades once you air out the room but returns within a day or two, mold is almost certainly the culprit — not just general stuffiness.
How Different Types of Mold Smell
Not all mold smells the same. Each species produces its own blend of volatile compounds, which means the odor in your bathroom might be noticeably different from the one lurking behind your kitchen cabinets. Understanding what does mold smell like across different species can help you gauge what’s growing before you ever see it.
Aspergillus is one of the most common indoor molds, and it tends to give off a stale, slightly sweet smell — almost like decaying leaves mixed with old bread. It thrives on walls, insulation, and even food. The sweetness comes from specific alcohols and ketones the fungus releases as metabolic byproducts.
Cladosporium leans more earthy. Think wet soil after rain, but sharper. It colonizes fabrics, wood surfaces, and HVAC systems, and its odor often intensifies when humidity spikes. You’ll notice it most on cool, damp surfaces like window sills.
Stachybotrys chartarum — the infamous black mold — produces a heavy, rotten smell that many describe as chemical-like or acrid. This species releases trichothecene mycotoxins alongside its odor compounds, which is partly why the smell feels harsh in your nose and throat. According to the U.S. Environmental Protection Agency, all mold should be treated seriously regardless of species, but Stachybotrys warrants particular caution.
Penicillium often carries a sour, tangy edge — close to fermented fruit or blue cheese. That’s no coincidence; the same genus gives us penicillin and certain aged cheeses. In homes, it favors water-damaged carpeting and wallpaper. The sour note intensifies as the colony matures and moisture persists.
Why such variety? Each species metabolizes organic material differently, producing unique cocktails of alcohols, aldehydes, and sulfur compounds. A sweet smell doesn’t mean the mold is harmless, and a faint odor doesn’t mean the colony is small. Smell is a clue, not a diagnosis.
Why Mold Produces a Musty Odor and What MVOCs Are
Mold doesn’t just sit there looking ugly. It eats. As mold colonies digest organic materials — wood, drywall paper, carpet fibers, even dust — they release chemical byproducts called microbial volatile organic compounds, or MVOCs. These airborne chemicals are what your nose actually detects when you walk into a room and immediately think “something’s off.” So when people ask what does mold smell like, the answer is really: you’re smelling the metabolic exhaust of a living organism breaking down your home.
Researchers have identified over 200 distinct MVOCs produced by indoor mold species. Some of the most common include 1-octen-3-ol (often called “mushroom alcohol”), geosmin, and 2-methylisoborneol. Geosmin is the same compound responsible for that earthy smell after rain. According to the U.S. Environmental Protection Agency, MVOCs can be present even at mold concentrations too low to see, which is why odor sometimes serves as the earliest warning sign of a hidden problem.
Several factors dial the smell up or down. Humidity above 60% accelerates mold metabolism, which means more MVOCs pumping into your air. Warmer temperatures — particularly between 77°F and 86°F — push colonies into their most active growth phase, intensifying the odor significantly. A cooler, drier room might mask the problem for weeks until conditions shift again.
Growth stage matters too. Young colonies in their early expansion phase tend to produce lighter, almost sweet-chemical odors. Mature colonies with heavy sporulation generate that thick, unmistakable mustiness. Dying or dormant mold can still off-gas MVOCs, just at reduced levels. The smell fading doesn’t mean the mold is gone — it may simply mean conditions temporarily slowed it down.
Mold Smell vs. Mildew Smell and How to Tell the Difference
People use “mold” and “mildew” interchangeably, but they’re not the same organism — and they don’t smell the same either. Mildew is a surface-level fungus that typically grows flat on damp materials like shower tiles, window sills, or wet fabric. Mold, by contrast, penetrates deeper into materials and forms thicker, more complex colonies. That structural difference directly affects the intensity and character of the odor each one produces.
Mildew smells damp. Think of a wet towel left crumpled in a hamper for two days — stale, slightly sour, but relatively faint. You can usually air out a mildew smell within hours. Mold is a different beast. Active mold growth generates a heavier, more pungent odor that clings to fabrics, furniture, and even your hair after you leave the room. If you’re trying to figure out what does mold smell like compared to mildew, the key distinction is persistence: mold’s smell doesn’t go away when you open a window.
Here’s a practical test. Stand in the room and breathe normally. If the smell is faint and disappears once airflow improves, you’re likely dealing with mildew. If the odor is sharp, earthy, and seems to intensify when heating or cooling systems run, that points toward established mold growth behind walls or under flooring. According to the EPA’s guide on mold and moisture, both require moisture control — but mold typically demands more aggressive remediation than a simple surface wipe.
Another clue: location. Mildew tends to stay where you can see it — grout lines, exposed pipes, damp clothing. Mold hides. It thrives inside wall cavities, beneath carpet padding, and around leaky plumbing joints. So if the smell is strong but you can’t find a visible source, assume mold until proven otherwise.
Where to Look When You Smell Mold but Cannot See It
You catch that stale, earthy whiff every time you walk into a room — but the walls look clean, the ceiling is spotless, and nothing seems off. This is frustrating, and it’s incredibly common. Mold thrives in hidden cavities where moisture collects undisturbed, sometimes growing for months before anyone notices. Knowing what does mold smell like is only half the battle; the other half is tracking the source down.
A Room-by-Room Approach
Bathrooms: Pull back caulking around tubs and shower pans. Mold frequently colonizes the backside of tile walls where grout has cracked, allowing shower water to seep into drywall. Check beneath the sink vanity — a slow P-trap drip can feed a colony for years.
Kitchen: Look under the sink first, especially around the garbage disposal connection and supply line valves. Then check behind the refrigerator where the drip pan sits. Dishwasher supply lines that run through adjacent cabinetry are another notorious culprit.
Bedrooms and living areas: Carpet padding traps moisture against the subfloor, particularly along exterior walls. Peel back a corner near windows or sliding doors. Window frames with failed seals let condensation run into the wall cavity below — a spot you’d never see without removing trim.
Basement and crawl space: The EPA identifies crawl spaces as one of the most common hidden mold locations in residential buildings. Check rim joists, vapor barriers, and any fiberglass insulation touching foundation walls.
The Professional Sniff-and-Search Method
Inspectors use a systematic grid technique. Close all windows and doors, then let the room sit sealed for 30 minutes. Start at the lowest point — baseboard level — and move your nose slowly along the wall in a zigzag pattern. The odor intensifies sharply within 6 to 12 inches of the source. Mark any hot spots with painter’s tape. HVAC supply and return registers deserve special attention; mold inside ductwork pushes that musty smell into every room the system serves, making the origin seem impossible to pin down.
If the smell persists but you still can’t locate it visually, a moisture meter reading above 16% on drywall is a strong indicator that mold is growing behind the surface. At that point, cutting a small inspection hole is usually the fastest path to confirmation.
Health Risks of Breathing in Mold Odor
That musty smell isn’t just unpleasant — it’s a warning. The microbial volatile organic compounds (MVOCs) responsible for what does mold smell like are themselves irritants, and breathing them in over weeks or months can trigger real health problems. A single whiff in a damp closet probably won’t hurt you. But chronic exposure in a bedroom or office where you spend 6 to 8 hours daily is a different story entirely.
Short-term symptoms often mimic a cold that never quite goes away: scratchy throat, watery eyes, persistent headaches, nasal congestion. Some people develop skin rashes or sinus pressure they can’t explain. According to the U.S. Environmental Protection Agency, mold exposure can worsen asthma symptoms, provoke allergic reactions, and irritate the upper respiratory tract even in otherwise healthy adults.
Certain groups face disproportionate risk. Children under five have smaller airways and faster breathing rates, which means they inhale more MVOCs per pound of body weight. Adults over 65 and anyone with a compromised immune system — organ transplant recipients, people undergoing chemotherapy, those living with HIV — can develop serious fungal infections from species like Aspergillus that healthier individuals might shrug off. Pregnant women also warrant extra caution, as some research links prolonged mold exposure to increased respiratory issues in newborns.
The distinction matters: occasional exposure during a basement cleanup is manageable with basic ventilation. Living inside a home where you consistently detect what mold smells like — that earthy, damp odor that greets you every morning — means your body is absorbing these compounds around the clock. If symptoms persist after two weeks and no other cause is obvious, get both yourself and your home evaluated.
What to Do When Your House Smells Like Mold
You’ve identified the smell. Now act fast. The longer mold grows unchecked, the deeper it penetrates porous materials like drywall, carpet padding, and wooden studs — turning a minor cleanup into a costly renovation.
Immediate Steps in the First 24 Hours
Open windows and run exhaust fans to flush out stale air. If you have a dehumidifier, set it to hold indoor humidity below 50%. Grab a cheap pin-type moisture meter (around $25–$40 at any hardware store) and probe the walls, floors, and trim near where the odor is strongest. Readings above 17% moisture content in wood or drywall signal a problem zone worth investigating further.
Confirm Before You Demolish
Don’t rip open walls based on smell alone. Home mold testing kits — the kind where you send a sample to an accredited lab — cost $30–$50 and can identify the species present. Air-sampling cassettes give more reliable results than settle-plate tests. If you’re wondering what does mold smell like versus a simple plumbing issue or stale HVAC air, a lab result removes the guesswork entirely.
DIY Cleanup vs. Professional Remediation
The EPA’s guideline is straightforward: if the affected area is smaller than about 10 square feet (roughly a 3×3-foot patch), most homeowners can handle it with detergent, water, and proper PPE — an N95 respirator, gloves, and goggles. Anything larger, or anything involving HVAC contamination, sewage backup, or immunocompromised household members, warrants a certified mold remediation specialist. Expect professional remediation to run $1,500–$5,000 depending on scope, though extensive structural damage can push costs much higher.
One critical detail: fix the moisture source first. Killing visible mold without stopping the water intrusion guarantees regrowth within weeks. Whether it’s a leaking pipe, poor grading around your foundation, or condensation from an uninsulated cold-water line, the water problem is always the root cause.
How to Prevent Mold Smell from Coming Back
Killing mold is half the job. The other half — the harder half — is making sure it stays gone. Mold spores are everywhere, floating through your air right now. They only need two things to colonize: moisture and an organic surface. Remove the moisture, and you starve them out.
Keep Indoor Humidity Below 50%
The EPA recommends maintaining indoor relative humidity between 30% and 50%. A $15 hygrometer from any hardware store lets you monitor this in real time. In humid climates, a whole-house dehumidifier connected to your HVAC system is far more reliable than portable units that need constant emptying. Basements and crawl spaces deserve their own dedicated dehumidifiers — these areas often sit 10–20% higher in humidity than the rest of the house.
Ventilate Aggressively
Bathrooms need exhaust fans rated at a minimum of 50 CFM, and those fans should run for at least 20 minutes after every shower. Kitchens produce surprising amounts of steam — a range hood vented to the outside (not recirculating) makes a real difference. Crack a window when weather allows. Stagnant air is mold’s best friend.
Maintain Your HVAC System
Replace filters every 60–90 days. Have ductwork inspected annually for condensation or leaks. Drip pans under air handlers collect standing water that breeds mold colonies fast, so check them each season.
Use Mold-Resistant Materials During Renovations
If you’re remodeling a bathroom or basement, swap standard drywall for mold-resistant (purple or green board) alternatives. Mold-resistant paint adds another layer of protection on walls prone to condensation. These materials won’t make a home mold-proof, but they buy significant time before growth takes hold.
Build a Seasonal Inspection Routine
Twice a year — once in spring, once in fall — walk through your home specifically looking and sniffing for trouble. Check under sinks, around window frames, behind appliances, and inside closets on exterior walls. Knowing what does mold smell like gives you an early detection tool that costs nothing. Catch moisture problems at this stage, and you’ll never need to deal with a full-blown mold remediation again.
Frequently Asked Questions About Mold Smell
Can mold grow without producing any smell?
Yes. Small, early-stage colonies often release so few MVOCs that your nose can’t detect them. A patch of mold behind drywall might grow for weeks before the concentration of airborne compounds reaches a noticeable level. This is exactly why visual inspections and moisture meters matter — smell alone isn’t a reliable early warning system.
Does a musty smell always mean mold?
Not necessarily. Stagnant water in a drain trap, decomposing organic debris in an HVAC system, or even old books stored in humid conditions can produce similar odors. That said, a persistent musty smell in a specific area of your home deserves investigation. Treat it as mold until you can prove otherwise.
Can air fresheners or candles mask dangerous mold odors?
They can cover the smell temporarily. They do absolutely nothing about the spores, MVOCs, or structural damage happening behind the scenes. The EPA explicitly warns against relying on deodorizers as a mold solution. Masking the odor actually makes things worse because it removes your main early-detection signal while the colony keeps spreading.
How quickly does mold develop a noticeable smell?
Mold can colonize a damp surface within 24 to 48 hours, but the characteristic musty odor usually takes longer — often 3 to 7 days under warm, humid conditions. If you’re wondering what does mold smell like at this early stage, think faintly stale air rather than an overpowering stench. The odor intensifies as the colony matures and its metabolic output increases.
Will the smell disappear once the mold is removed?
Mostly, but not always immediately. MVOCs can linger in porous materials like carpet padding, fabric, and unsealed wood even after the visible mold is gone. Thorough cleaning, proper ventilation, and sometimes replacing saturated materials are needed before the air smells completely clean again. If the odor persists more than a week after professional remediation, residual moisture or a second hidden colony could be the culprit.
Trust Your Nose and Take Action Early
Your nose is remarkably good at detecting trouble. If a room smells earthy, damp, or stale — like wet cardboard left in a closet for weeks — that’s your cue. Understanding what does mold smell like gives you a genuine head start, because odor often appears long before visible growth does. The musty scent comes from MVOCs, gaseous byproducts of active mold metabolism, and it means colonies are feeding and spreading right now.
Here’s what matters most. The smell points you to the source: check behind walls, under sinks, around HVAC systems, and inside any space where moisture lingers. A $30 moisture meter can confirm your suspicion in seconds. If the affected area exceeds 10 square feet, the EPA recommends hiring a professional remediator rather than tackling it yourself.
Speed changes everything. Mold can colonize drywall in 24 to 48 hours after water exposure. A small patch behind a bathroom tile today becomes a full wall problem in three weeks. Meanwhile, the MVOCs you’re breathing may trigger headaches, respiratory irritation, and worsening allergy symptoms — effects that compound with prolonged exposure.
Don’t rationalize the smell away. Don’t mask it with air fresheners. Investigate it. Test it. Fix the moisture source, remove the growth, and then keep humidity below 50% so it stays gone. A persistent musty odor is your home asking for help. The sooner you respond, the less it costs — in money, in health, and in structural damage you can’t easily undo.
See also
Pressure Vessel Weld Cleaning: The Complete Guide
How to Prevent Weld Rust on Metal Surfaces Effectively
3 ways fatal damage to equipment happens with laser voltage